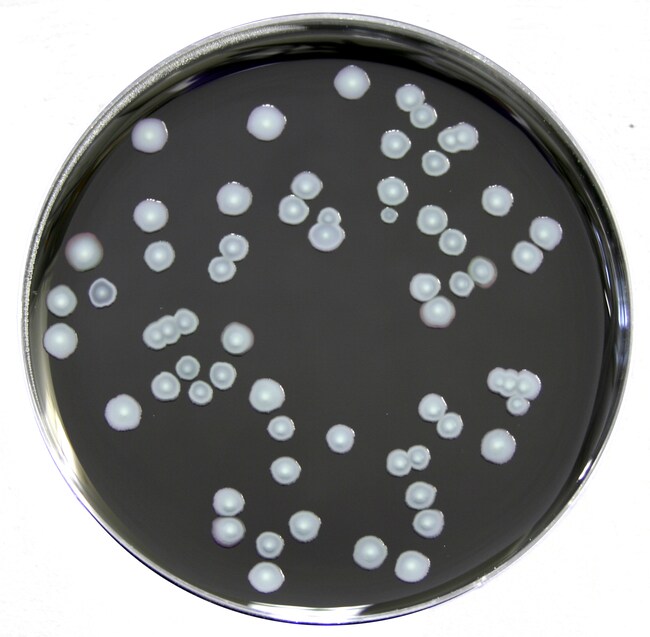
oxoid&trade; 军团菌 bcye 添加剂

bcye培养基

产品详情页-life technologies
图片尺寸650x600
科玛嘉 军团菌bcye-c板ye琼脂平 琼脂平皿培养基 9cm 20个/盒
图片尺寸800x800
bcye培养基原理及实验现象
图片尺寸227x228
以色列bi基础培养基
图片尺寸640x432
液体培养基基础
图片尺寸2983x1584
10个/包bcye琼脂平板(9cm)用途:用于军团菌的选择性分离培养bcye琼脂
图片尺寸709x709
gibco:rpmi 1640 培养基,c11875500bt
图片尺寸3456x3456
含900ml缓冲蛋白胨水(bpw)均质袋
图片尺寸2816x2112
oxoid™ 军团菌 bcye 添加剂
图片尺寸650x637
rpmi 1640 medium1640培养基11875093,500ml
图片尺寸1920x1920
军团菌bcye平板 9cm培养基 用于军团菌的选择性分离培养 芜湖欧克
图片尺寸800x800
日水培养基图片_企业相册-青岛日水生物技术有限公司
图片尺寸1800x1668
500ml bioexplorer bme基础培养基
图片尺寸3024x4032
有没有做过嗜肺军团菌的朋友,求bcye上嗜肺军团菌图片
图片尺寸1944x2592
dmem高糖培养基 -上海儒安生物科技有限公司
图片尺寸2106x2106
麦康凯琼脂培养基
图片尺寸3872x2592
gbs显色培养基 胡箩卜素显色培养基 早发性b群链球菌疾病
图片尺寸1478x1109
yy/t 1209-2013 bcye琼脂培养基
图片尺寸800x800
bcye琼脂基础公共场所卫生消毒验证嗜肺军团菌干粉培养基100g/瓶 bcye
图片尺寸800x800
6767676767676767676767南京生
图片尺寸2448x2448